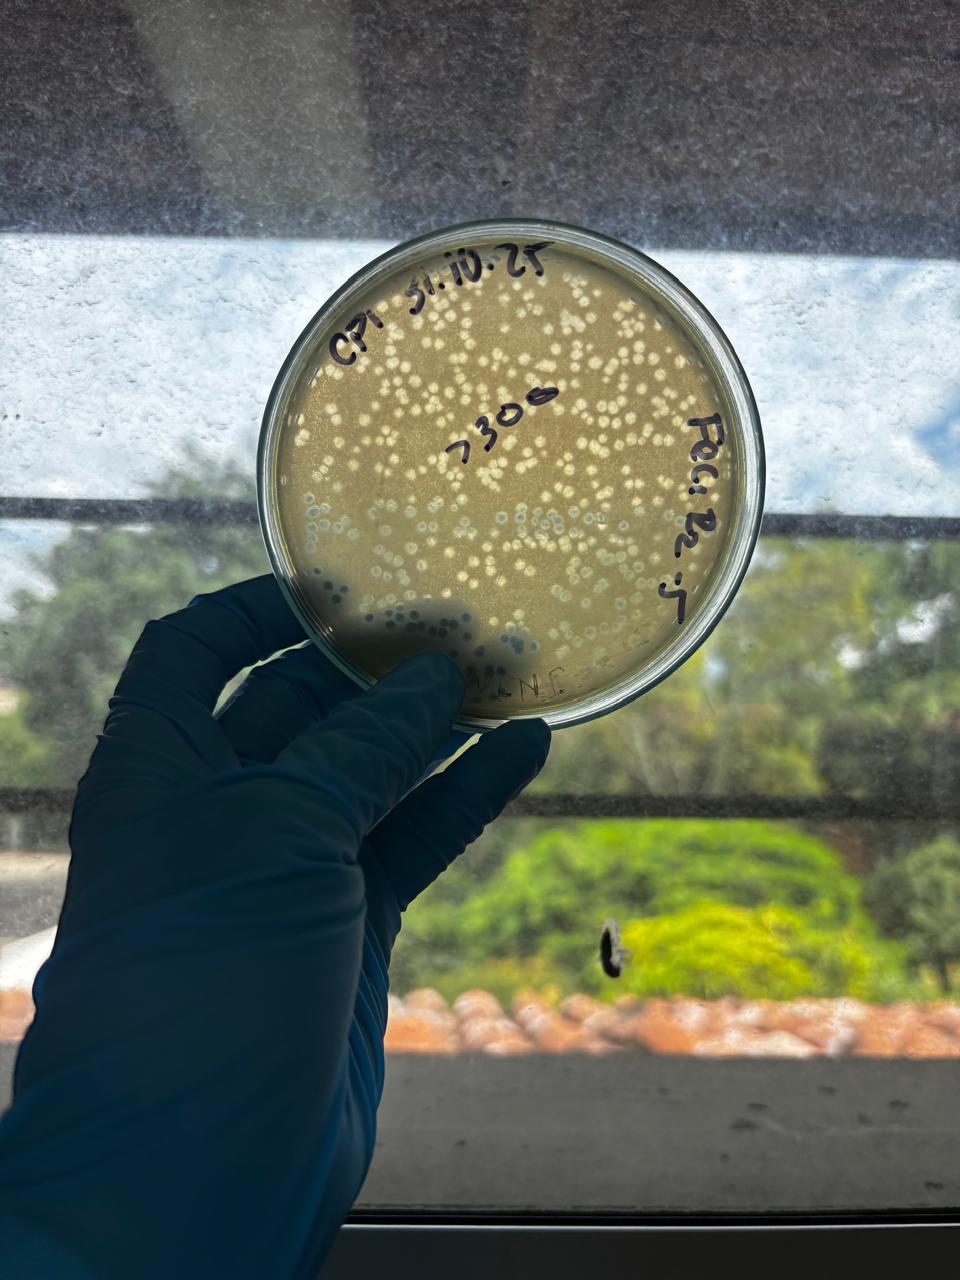
Laboratorio de investigación PhageLife - Caracterización de bacteriófagos

Salud que se multiplica
En PhageLife integramos bioprospección, caracterización genómica y formulación avanzada para el desarrollo de bacteriófagos líticos dirigidos al control de bacterias multirresistentes relevantes en producción animal.
El desarrollo de soluciones efectivas inicia con la identificación de fagos adaptados a las condiciones locales. Nuestro enfoque se basa en la bioprospección en entornos donde coexisten bacterias patógenas y sus fagos naturales.
Cada candidato es sometido a análisis bioinformático para garantizar:
Los bacteriófagos eliminan bacterias mediante un ciclo lítico altamente específico:
La interacción fago-bacteria depende de estructuras específicas de la superficie bacteriana. Esta alta especificidad reduce efectos no deseados sobre microorganismos no objetivo.
A diferencia de los antimicrobianos convencionales, los fagos pueden multiplicarse en presencia de su bacteria objetivo, lo que favorece su acción en focos de infección activa. Una vez disminuye la población bacteriana, su replicación se reduce de forma natural.
Para mejorar la robustez de las soluciones, PhageLife desarrolla combinaciones de múltiples fagos (cócteles), diseñadas para:
El uso de múltiples fagos con diferentes mecanismos de reconocimiento disminuye la probabilidad de escape bacteriano, al requerir múltiples cambios simultáneos en la bacteria.
La tecnología fágica de PhageLife es compatible con otras estrategias de control sanitario, permitiendo su integración en programas de manejo existentes en producción animal.
La tecnología de PhageLife no se limita al aislamiento de fagos, sino que integra:
PhageLife desarrolla soluciones basadas en evidencia científica para enfrentar el desafío de la resistencia antimicrobiana, contribuyendo a sistemas productivos más eficientes, seguros y sostenibles.

El Centro de Investigación y Desarrollo en Biotecnología y Bioinnovación — BIOPHAGE es una unidad científica creada por PhageLife S.A.S., empresa biotecnológica con sede en Medellín (Colombia), enfocada en el desarrollo de soluciones basadas en bacteriófagos para la salud animal, humana y ambiental. El centro integra investigación básica, aplicada y desarrollo tecnológico para generar conocimiento transferible, innovación productiva y soluciones sostenibles bajo el enfoque One Health.
La resistencia antimicrobiana (RAM) es una de las principales amenazas sanitarias y económicas a nivel mundial. En la producción pecuaria intensiva, el uso profiláctico y terapéutico de antibióticos ha acelerado la aparición de bacterias multirresistentes, afectando la eficacia terapéutica, la seguridad alimentaria y la sostenibilidad ambiental. Este contexto exige alternativas biotecnológicas que reduzcan la dependencia de antimicrobianos convencionales.
La fagoterapia, basada en el uso de bacteriófagos específicos contra bacterias patógenas, ha resurgido como una estrategia de alto potencial. Países como Estados Unidos, Bélgica, Georgia e Israel han desarrollado aplicaciones clínicas y agroindustriales, incluyendo cócteles fágicos personalizados, su implementación en producción avícola y porcina, y el uso de enzimas derivadas de fagos.
En América Latina, el desarrollo de esta biotecnología aún es incipiente, con brechas en aislamiento de fagos nativos, escalamiento productivo, validación regulatoria y transferencia tecnológica. En Colombia, pese a contar con sólidas capacidades académicas, el desarrollo industrial es emergente. BIOPHAGE busca cerrar estas brechas, fortalecer la bioeconomía nacional y promover la sustitución progresiva de antimicrobianos mediante soluciones científicamente validadas, viables y sostenibles.